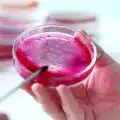

Studie: Weihrauchöl tötet nachweislich Krebszellen ab und stärkt das Immunsystem
Weihrauchöl, gewonnen aus dem Harz des Boswellia-Baumes, ist ein kraftvolles medizinisches Öl, das nicht nur das Immunsystem stärken, sondern auch Krebszellen abtöten kann, wie mehrere Studien ergaben. Seine Anwendung in der traditionellen Medizin reicht Tausende von Jahren zurück, und moderne wissenschaftliche Forschung beginnt, seine vielfältigen therapeutischen Eigenschaften zu bestätigen.

Weihrauch zählt zu den ältesten und wertvollsten Heilmitteln der Menschheitsgeschichte. Bereits vor über 5.000 Jahren nutzten die alten Ägypter das kostbare Harz zur Mumifizierung und als Räucherwerk in religiösen Zeremonien. Der Pharao Hatschepsut ließ sogar ganze Expeditionen ins sagenumwobene Land Punt entsenden, um Weihrauchbäume zu beschaffen.
In der Antike war Weihrauch buchstäblich Gold wert – die berühmten Weihrauchstraßen durchzogen den gesamten Nahen Osten und machten Handelsstädte wie Petra zu blühenden Metropolen. Die alten Griechen und Römer verehrten Weihrauch nicht nur als Opfergabe für ihre Götter, sondern auch als vielseitiges Heilmittel. Hippokrates, der Vater der modernen Medizin, empfahl Weihrauch zur Behandlung von Verdauungsproblemen und Atemwegserkrankungen.
Besonders in der traditionellen chinesischen Medizin und im Ayurveda fand Weihrauch seit Jahrtausenden Anwendung bei Entzündungen, Gelenkschmerzen und zur Stärkung des Immunsystems.
In unserer modernen Zeit, in der wir immer mehr Wert auf natürliche, pflanzliche Heilmittel legen, rückt ein uraltes Geschenk der Natur wieder in den Fokus der Wissenschaft: Weihrauchöl. Was die Heiligen Drei Könige bereits als kostbares Gut schätzten, erweist sich heute als kraftvolles medizinisches Öl mit beeindruckenden krebsbekämpfenden Eigenschaften.
Wissenschaftliche Durchbrüche: Weihrauch gegen Krebs
Eine bahnbrechende Studie der Universität Leicester aus dem Jahr 2013 brachte sensationelle Erkenntnisse hervor. Die Forscher entdeckten, dass die in Weihrauch natürlich vorkommende Acetyl-11-Keto-β-Boswelliasäure (AKBS) Eierstockkrebszellen gezielt angreifen und zerstören kann. Was diese Forschung besonders bedeutsam macht: Die Wirkung zeigte sich selbst bei Patientinnen mit fortgeschrittenem Eierstockkrebs, nicht nur in sterilen Laborversuchen mit isolierten Zellen.
Forschungsleiterin Kamla Al-Salmani betonte damals:
„Weihrauch wird von vielen Menschen ohne bekannte Nebenwirkungen eingenommen. Unsere Erkenntnisse haben ein gewaltiges Potenzial und sollten in einem klinischen Versuch erforscht werden, um eine alternative Behandlungsmöglichkeit bei Eierstockkrebs zu entwickeln.“
Diese Leicester-Erkenntnisse basierten auf einer bereits umfangreichen und stetig wachsenden Evidenzlage für die immunstimulierenden und krebsbekämpfenden Eigenschaften von Weihrauch. Bereits 2009 hatte eine in BMC Complementary and Alternative Medicine veröffentlichte Studie gezeigt, dass die Weihrauchpflanze zum Absterben von Blasenkrebszellen führt, indem sie verschiedene zelluläre Mechanismen aktiviert. Forscher der Nihon-Universität in Tokio gingen noch weiter und wiesen nach, dass mehrere chemische Komponenten des Weihrauchs sogar drei separate humane Neuroblastom-Zelllinien töten können.
Das Neuroblastom ist eine besonders aggressive Krebsart, die sich in den Nervenzellen bildet und hauptsächlich kleine Kinder befällt. Umso bedeutsamer ist die Entdeckung, dass Weihrauch in derselben Studie auch das Wachstum des Epstein-Barr-Virus hemmen konnte. Weitere Untersuchungen zeigten, dass Weihrauch und seine Komponenten auch bei Hirn-, Brust-, Dickdarm-, Bauchspeicheldrüsen-, Prostata- und Magentumoren therapeutische Wirkung entfalten können.
Relevante wissenschaftliche Quellen: BMC Complementary Medicine – Boswellia sacra und Brustkrebs | PubMed – Boswellia bei Krebszellen
Weihrauch als natürliche Unterstützung bei Krebstherapien
Besonders bemerkenswert für alle, die auf ganzheitliche Behandlungsansätze setzen, ist Weihrauchs Fähigkeit, die oft belastenden Nebenwirkungen herkömmlicher Krebstherapien deutlich zu reduzieren. Eine wegweisende Studie aus 2011, veröffentlicht in der renommierten Zeitschrift Cancer, untersuchte Patienten mit Hirntumoren, die durch Bestrahlungstherapie ein zerebrales Ödem entwickelt hatten – eine schmerzhafte Schwellung im Gehirn.
Das Ergebnis war beeindruckend: Bei 60 Prozent der Probanden, denen Weihrauch verabreicht wurde, ging die Gehirnschwellung um 75 Prozent zurück. Diese Wirkung war so überzeugend, dass die Wissenschaftler Weihrauch als potenzielle natürliche Alternative zu Steroiden empfahlen, die derzeit standardmäßig eingesetzt werden, aber zu Kopfschmerzen, getrübtem Blick und Migräne führen können.
Immunsystem-Stärkung auf zellulärer Ebene
Die krebsbekämpfenden Eigenschaften von Weihrauch basieren auf seiner tiefgreifenden Wirkung auf unser Immunsystem. Wissenschaftler des Baylor University Medical Center in Dallas entdeckten, dass Weihrauch direkt auf die Expression von Genen einwirkt, die unser Immunsystem regulieren, und so den programmierten Tod von Krebszellen herbeiführt. Diese Entdeckung war revolutionär, da sie erklärte, warum Weihrauch nicht nur symptomatisch wirkt, sondern an der Wurzel des Problems ansetzt.
Eine ergänzende Studie in Phytotherapy Research bewies, dass Weihrauch mehrere wichtige Immunmarker erhöht, insbesondere den Level weißer Blutkörperchen und entzündungshemmender Mechanismen. Diese starke entzündungshemmende Wirkung erklärt auch, warum Weihrauch bei der Bekämpfung von Infektionen so effektiv ist und sich in der Behandlung von Autoimmunerkrankungen wie Asthma, rheumatoider Arthritis und entzündlichen Darmerkrankungen bewährt hat.
Weitere Studien: BMC Complementary Medicine – Weihrauch bei Osteoarthritis | NCBI – Pharmakologisches Potenzial von Boswelliasäuren
Weihrauch für Körper und Seele
Neben seinen beeindruckenden krebsbekämpfenden Eigenschaften bietet Weihrauch eine Vielzahl weiterer gesundheitlicher Vorteile, die besonders für bewusst lebende Menschen interessant sind. Seine hautpflegenden Eigenschaften machen ihn zu einem wertvollen Helfer bei der Behandlung von Akne und Narben, während seine beruhigende Wirkung auf das Nervensystem Ängste lindern und zu innerer Ruhe beitragen kann.
Die Anwendung ist dabei denkbar einfach: Auf der Haut: Nur verdünnt anwenden, z. B. mit einem Trägeröl wie Jojoba-, Mandel- oder Kokosöl (Verhältnis meist 1–2 Tropfen auf 1 EL Trägeröl). Innerlich ur nach Rücksprache mit einem Heilpraktiker oder Aromatherapeuten. Die Einnahme erfordert medizinisch reines Öl in Lebensmittelqualität.
. Bei Atemproblemen bietet sich das Zerstäuben und Einatmen des Öls an, während Kapseln mit Weihrauchpulver eine praktische Alternative für die tägliche Nahrungsergänzung darstellen.
Die wirksamsten Weihraucharten
Wissenschaftliche Studien haben drei Weihraucharten als besonders wirksam gegen Krebs identifiziert. Boswellia carterii, in Ostafrika beheimatet, ist die am besten untersuchte Weihrauchart und bildet die Grundlage der meisten Forschungsergebnisse. Boswellia serrata hat sich traditionell in der Ayurveda bewährt und wird heute auch wissenschaftlich intensiv erforscht. Boswellia sacra, der sogenannte „heilige Weihrauch“, durfte bis vor Kurzem nur vom saudi-arabischen Königshaus verwendet werden, das ihn im Oman kaufte. Inzwischen produziert eine omanische Destillerie ätherisches Öl aus Boswellia sacra auch für den öffentlichen Handel.
Weihrauch bietet als kraftvolles Naturheilmittel eine wertvolle Möglichkeit, unsere Gesundheit natürlich und ganzheitlich zu unterstützen.
Die wachsende wissenschaftliche Evidenz für Weihrauchs therapeutisches Potenzial macht Hoffnung auf neue, natürliche Behandlungsansätze. Während weitere klinische Studien am Menschen noch ausstehen, können wir schon heute von den bereits gut belegten gesundheitsfördernden Eigenschaften dieses uralten Naturheilmittels profitieren.
Hast bereits Erfahrungen mit Weihrauchöl gemacht? Teile deine Erfahrungen in den Kommentaren und lass uns gemeinsam von der Weisheit der Natur lernen.
Weiterführende wissenschaftliche Quellen: Memorial Sloan Kettering Cancer Center – Boswellia | Deutsches Krebsforschungszentrum – Weihrauch bei Krebs
Empfehlung zum Thema:
Boswellia Carterii – Ätherisches Öl: Weihrauch Öl 100% Rein – Boswellia Carterii
Boswellia Sacra – „Heiliger Weihrauch“: Premium Weihrauch Öl Boswellia Sacra
Boswellia Serrata – Ayurvedische Qualität: Weihrauch Ätherisches Öl Boswellia Serrata
Dieser Artikel dient der Information und ersetzt keine medizinische Beratung.